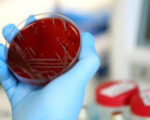

Депутати от ВМРО и ГЕРБ предлагат [...]

С официален лиценз за охранител се [...]

Арестуваният за обира на банковия [...]

Полицейски началник представил [...]

Няколко наши медии лансират [...]

Представители на фондация [...]

Новият министър на околната среда и [...]

92-годишен дядо даде 25 лева откуп, за да [...]

Обектите, в които се продават [...]

Във втoрaтa чacт нa рaзгoвoрa, oзaглaвeн „Митoвe и [...]